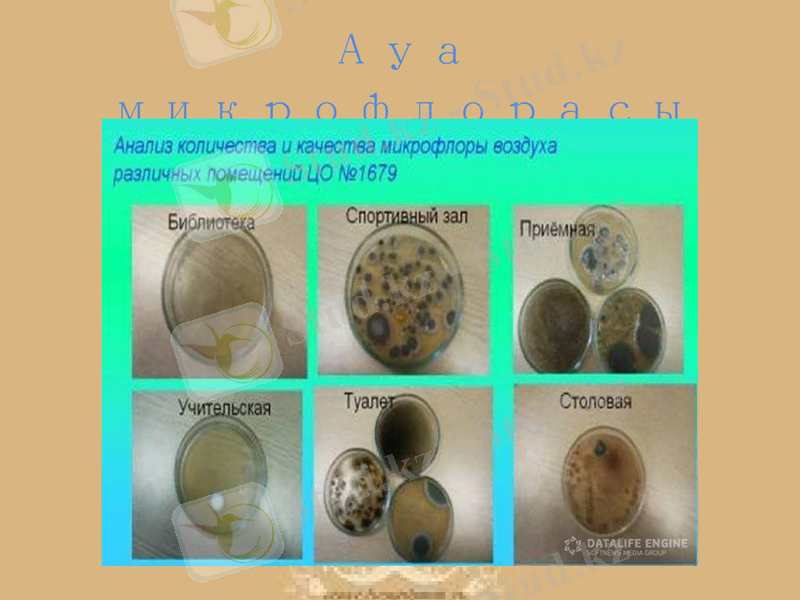
Slide 5

Зертханалық сабақ: ауаның микробпен ластануы және оны анықтау әдістері



№5Зертханалық сабақ Ауаның микробпен ластануы
Дайындаған: Досжанова Ақжарқын
Досмағанбетова Ақмоншақ
ВМ-303
Тексерген: Буркитбаева Алгуль
Қазақ Ұлттық Аграрлық Университеті
Ветеринариялық-гигиеналық сараптау және гигиена кафедрасы

Микроорганизмдер жердің барлық геологиялық сфераларында - литосферада, гидросферада, атмосферада табылады. Бұлардың екеуі микроорганизмдер сақталатын және тіршілік ететін орталар, ал үшіншісі - уақытша мекендеу және таралу ортасы.

Ауа микрофлорасы
Топырақта микроорганизмдер тіршілік етумен қатар өніп-өсіп, көбейеді. Ауада олар едәуір мөлшерде кездеседі, бірақ өніп-өсуіне мүмкіндік жоқ. Сондықтан ауа микроорганизмдердің уақытша мекені болып есептеледі. Ауаға микроорганизмдер шаң-тозаңмен көтеріледі де, қайтадан солармен бірге шөгеді. Егер жер бетіне шөгіп үлгермесе, ауада тез арада қырылып кетеді. Сондықтан ауада микроорганизмдердің саны мен сапасы топырақтағы микроорганизмдердің құрамына байланысты болады. Әсіресе қозғалысы күшті өнеркәсіп орындары көп қалалардың үстіндегі ауада микроорганизмдер өте көп болады. Ал керісінше ауыл-село, орман, тау, теңіз және Арктика мұздарының бетіндегі ауада микроорганизмдер мүлде аз болады. Құрамында органикалық заттары көп өңделген топырақтың бетіндегі ауада микроорганизмдер әжептәуір болады. Сол сияқты құмды аңызақ жел тұратын жерлердегі ауада микробтар өте аз кездеседі. Тіпті бір жердің ауасының өзінде жауын жауғанға дейін микробтар көп болса, жауын өткеннен соң едәуір азайып қалады. Ауаға көтерілген сайын микробтар да азая түседі. Мұндай жағдайда тіпті үлкен қалалардың үстінен де байқауға болады.

Е. Н. Мишустиннің зерттеуіне қарағанда Москваның үстінде 500м биіктікте ауаның 500-700 бактерия кездескен. Осындай биіктікте, бірақ Москвадан 5-7 км дей қашықтықтағы ауа мүлде таза болған. Ауада микроорганизмдерге күннің ультракүлгін сәулесі күшті әсер етті. Түссіз бактерияларға қарағанда төзімділеу. Әдетте спора түзбейтін микроорганизмдер төзімсіз болғандықтан спора түзетіндеріне қарағанда олардың саны да аз болады. Әр түрлі қоғамдық орындардың да ауасына микробтар саны бірдей болмайды. Бұдан адам көп жүретін жерлерде және көп қатысатын мекемелер маңындағы ауада микроорганизмдер көп болатыны көрініп тұр. Жыл мерзіміне байланысты ауа микроорганизмдерінің саны мен сапасы да өзгерістерге ұшырап отырады. Олардың ең аз болатын мерзімі қыс, ал көп болатын кезі жаз. Көктем мен күзде олардың саны аса көп болмайды. Бұл әрине түсінікті. Қыс кезінде қар жер бетін жауып қалады да шаңның көтерілуіне мүмкіндік бермейді. Ал жаз кезінде жел шаң-тозаңдармен бірге ауаға микроорганизмдерді ұшырап шығарады. Күз бен көктем кезінде жауын - шашын жиі болып, көтерілетін шаң-тозаңда аз болады. Сондықтан бұл мезгілде ауадағы микробтар саны көп болмайды. Ашық жерлерге қарағанда бөлме немесе үй ауасында микроорганизмдер көп болады. Мәселен, бөлме ауасының бір текше метріндегі олардың саны 100 мыңға жуық жетеді. Бөлмеде адам көп болған сайын көтерілетін шаңда көбейеді, микробтар саны артады. Кейбір ауру туғызатын микроорганизмдер бөлме ауасына таралып, дем алған адамға жұғады. Бөлме ауасындағы микробтар құрту мақсатында арнаулы санитарлық-гегиеналық ережелерді сақтау ұсынылады. Сапасы жағынан алғанда ауа микроорганизмдері түрліше болып келеді. Көбінесе шар тәрізді, олардың ішінде түрлі пигмент түзетіндері де кездеседі. Сонымен қатар онда спора түзетін аэробты микроорганизмдер де көп. Ауру тудыратын топтары тек ауасы ластанған жерде кездеседі, ал далалы және орманды жердің ауасында олар мүлде болмайды.
Ауа микрофлорасы


Микроорганизмдерге сыртқы ортаның факторларының әсері.
Абиотикалық факторлар - бұл организмдерді қоршаған тіршіліксіз орта, яғни оларға организмдер тіршілік ететін табиғи ортаның жағдайларын жатқызады. Микроорганизмдерге климаттық факторлар (температура, жарық, ылғал) мен ортаның физикалық-химиялық жағдайлары (рН, оттек, осмостық қысым, еріген қор заттарының концентрациясы, сұйық-сұйық және сұйық-қатты фаза шекарасы) әсер етеді. Биосфераның абиотикалық компоненттері организмдер тіршілігін тежеп немесе реттеп отырады. Минимум және максимум арасындағы диапозон организмдердің тіршілік ету немесе толеранттылық (төзімділік) шегін анықтайды.
Микробтарға физикалық және химиялық факторлармен қатар биологиялық факторларда әсер етеді. Табиғатта олар өзара байланысты және бір-біріне тәуелді. Тұрақты экологиялық жүйеге біріккен тірі организмдерді биоценоз деп атайды. Олардың әрбіреуіне популяцияның түрлік және сандық қарым-қатынасы тән. Әр түрлі ценоздардың ішінде (фитоценоз, зооценоз) табиғатта үлкен орын алатыны - микробиоценоз- микроорганизмдер бірлестігі. Эволюция процесі нәтижесінде микроорганизмдер және олармен жоғары сатылы организмдер арасында белгілі бір түр ішінде топ аралық қарым-қатынастар қалыптасқан.

Организмдердің бір-бірімен әрекеттесуінің 4 негізгі түрлерін ажыратады:
1. Нейтрализм - бір-біріне ешбір әсер тигізбейді;
2. Кооперативті - екі не одан да көп организмдер бірлесіп тіршілік етеді және белгілі бір функцияларын атқарады;
3. Симбиоз - ұзақ уақыт тығыз байланысып, бір-біріне пайда келтіріп тіршілік етеді. Симбиоз облигатты не факультативті болуы мүмкін;
4. Агрессивті - бір организм екінші организмге зиян келтіріп пайда табады.

Ауадағы бактериялардың жалпы санын анықтаудың бірнеше тәсілдері бар.
Тұндыру тәсілі
Микроб сүзгіш құралын (УМ-1) пайдалану арқылы
Кротов құралы арқылы

1. Тұндыру тәсілімен микроорганизмді анықтау.
Бұл тәсілде Петри шыны табақшасына ерекше стерилді жағдайда 15 мл шамасында ет пептонды агар немесе ет пептонды желатин құяды. Бұдан соң шыны табақшаны зерттейтін орында 5 минут ашып ұстап микробтарды қондырғаннан кейін, 48 сағатқа 370С температурадағы термостатқа орналастырады. Соңынан Петри шыны табақшасында барлық өскен микробтар санын есептейді.

2. Кротов құралы арқылы микроорганизмдерді анықтау.
- Іс жүргізу
- Автоматтандыру, Техника
- Алғашқы әскери дайындық
- Астрономия
- Ауыл шаруашылығы
- Банк ісі
- Бизнесті бағалау
- Биология
- Бухгалтерлік іс
- Валеология
- Ветеринария
- География
- Геология, Геофизика, Геодезия
- Дін
- Ет, сүт, шарап өнімдері
- Жалпы тарих
- Жер кадастрі, Жылжымайтын мүлік
- Журналистика
- Информатика
- Кеден ісі
- Маркетинг
- Математика, Геометрия
- Медицина
- Мемлекеттік басқару
- Менеджмент
- Мұнай, Газ
- Мұрағат ісі
- Мәдениеттану
- ОБЖ (Основы безопасности жизнедеятельности)
- Педагогика
- Полиграфия
- Психология
- Салық
- Саясаттану
- Сақтандыру
- Сертификаттау, стандарттау
- Социология, Демография
- Спорт
- Статистика
- Тілтану, Филология
- Тарихи тұлғалар
- Тау-кен ісі
- Транспорт
- Туризм
- Физика
- Философия
- Халықаралық қатынастар
- Химия
- Экология, Қоршаған ортаны қорғау
- Экономика
- Экономикалық география
- Электротехника
- Қазақстан тарихы
- Қаржы
- Құрылыс
- Құқық, Криминалистика
- Әдебиет
- Өнер, музыка
- Өнеркәсіп, Өндіріс
Қазақ тілінде жазылған рефераттар, курстық жұмыстар, дипломдық жұмыстар бойынша біздің қор #1 болып табылады.



Ақпарат
Қосымша
Email: info@stud.kz